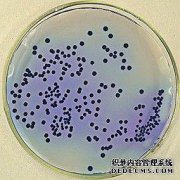
支原体对生殖健康危害大，如何将其“清除”干

-

孩子喊腰疼 也需警惕腰椎间盘突出
以往在人们的认知中,腰疼是重体力劳动者、老年人才有的专利,但是近年来的统计显示,有50%的腰椎疾病患者都是年轻人甚至是学生、孩子,尤其是在孩子反复喊腰疼时,也需...
2018-10-24查看详情
-

没胃口拉肚子消瘦齐出现 警惕直肠癌
一时的没胃口相想必很多人都有过此体验,但是若经常性的没胃口吃不下东西,且还伴随有频繁的拉肚子,短时间内消瘦厉害,那就需要警惕严重的胃肠道疾病,甚至还需警惕癌症可...
2018-10-24查看详情
-

说一句话打一次嗝 警惕膈肌痉挛症
吃东西过快过量、一次性喝太多的碳酸饮料等,都有可能出现打嗝,但是这种打嗝一般持续几秒、或几分钟后就会消失。但是若持续打嗝三个月,甚至每间隔1分钟就打嗝4--5次...
2018-10-24查看详情
-

乱吃东西不注意 最后寄生虫“附体”
寄生虫这种生物,可想而知就是寄宿在别的动物体上,并或多或少给寄主造成危害。看过关于寄生虫的电影,大概也可以想象到寄生虫是怎样的一种生活状态了吧,实际上等同于病毒...
2018-10-22查看详情
-

一口气吃太多五花肉 吃出急性胰腺炎
近期天气降温的厉害,大多数城市已经开启零度、零下的温度模式,于是不少人开始吃起火锅、啤酒、烧烤等,就连老年人也开始吃肉类补充体内的脂肪。这不,年过6旬的吴先生就...
2018-10-22查看详情
-

同时吃几种药对肾脏会有什么危害?
肾脏是药物及其代谢产物排泄的重要途径。药物的肾毒性程度不仅与药物毒力有关,而且与药物在肾脏的分布、代谢及排出的过程有关。
2018-10-20查看详情
-

养肾、保肾,要怎么做?
现如今肾脏病患者越来越多且呈现持续增长态势,身边也经常有朋友问我这样的问题,肾脏病如此可怕,应该如何养肾呢?
2018-10-20查看详情
-
支原体对生殖健康危害大,如何将其“清除”干
支原体作为一种寄居微生物,虽不是人人都有,但可在某些健康成年人当中携带,以及在有不洁性生活人群中检出率更高。 其中,健康成年人当中,支原体多居于女性阴道及子宫颈...
2018-10-20查看详情
-

男人早泄吃什么好?
男人早泄也属于性功能障碍之一,随着年龄的增长,早泄的发病率也会随之增高,它不仅影响夫妻之间的关系
2018-10-20查看详情
-

这种饮水方式也会伤害肾
肾健康与女性美丽有重要联系,肾脏不好,会造成干发、黑眼圈、手脚冰凉等症状
2018-10-20查看详情







